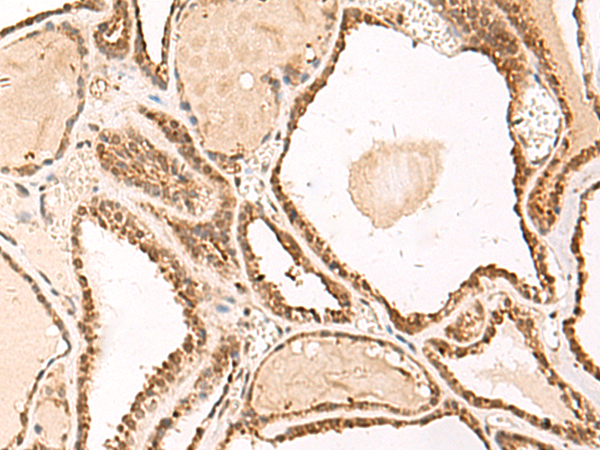
一抗

Background:
FUNDC2 (FUN14 domain-containing protein 2), also known as HCC-3 (cervical cancer proto-oncogene 3 protein), HCBP6 (hepatitis C virus core-binding protein 6) or DC44, is a 189 amino acid protein belonging to the FUN14 family. The gene encoding FUNDC2 maps to human chromosome Xq28. The X and Y chromosomes are the human sex chromosomes. Chromosome X consists of about 153 million base pairs and nearly 1,000 genes. The combination of an X and Y chromosome lead to normal male development while two copies of X lead to normal female development. More than one copy of the X chromosome with a Y chromosome causes Klinefelter's syndrome. A single copy of X alone leads to Turner's syndrome. More than 2 copies of the X chromosome, in the absence of a Y chromosome, is known as Triple X syndrome. Color blindness, hemophilia, and Duchenne muscular dystrophy are well known X chromosome-linked conditions which affect males more frequently as males carry a single X chromosome.
Applications:
ELISA, IHC
Name of antibody:
FUNDC2
Immunogen:
Fusion protein of human FUNDC2
Full name:
FUN14 domain containing 2
Synonyms:
DC44; HCC3; HCBP6; PD03104
SwissProt:
Q9BWH2
ELISA Recommended dilution:
5000-10000
IHC positive control:
Human tonsil and Human thyroid cancer
IHC Recommend dilution:
50-300


 購物車
購物車 幫助
幫助
 021-54845833/15800441009
021-54845833/15800441009